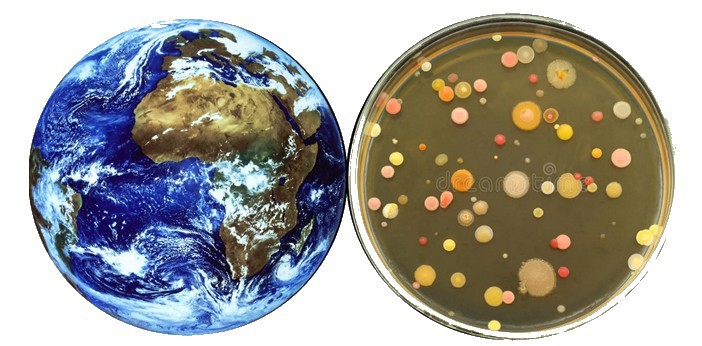

- Enseignant: Amina DERRADJIA
Cet enseignement permet la connaissance des relations existantes entre le microorganisme et le milieu constitué par les eaux, les sols ou le tube digestif de l’homme et de l’animal. Les principaux groupes de microorganismes (indicateurs ou spécifiques) dans ces différents écosystèmes et les interactions microbes-(faune, eaux, végétaux, sols) sont particulièrement étudiés. Le rôle des microorganismes dans les différents cycles de la matière vivante (cycles biogéochimiques des éléments) est également largement évoqué
- Enseignant: Hanane Oucif

S’initier à la recherche documentaire, apprendre à définir un thème de recherche, préciser une question de recherche, et choisir la méthode la plus adaptée pour y répondre.
- Enseignant: El Hadj Elandaloussi

Cours de Microbiologie Alimentaire, destine aux L3 Microbiologie.
Ce cours s intéresse a la relation existante entre les aliments et les micro-organismes.
- Enseignant: Nasrine Addi